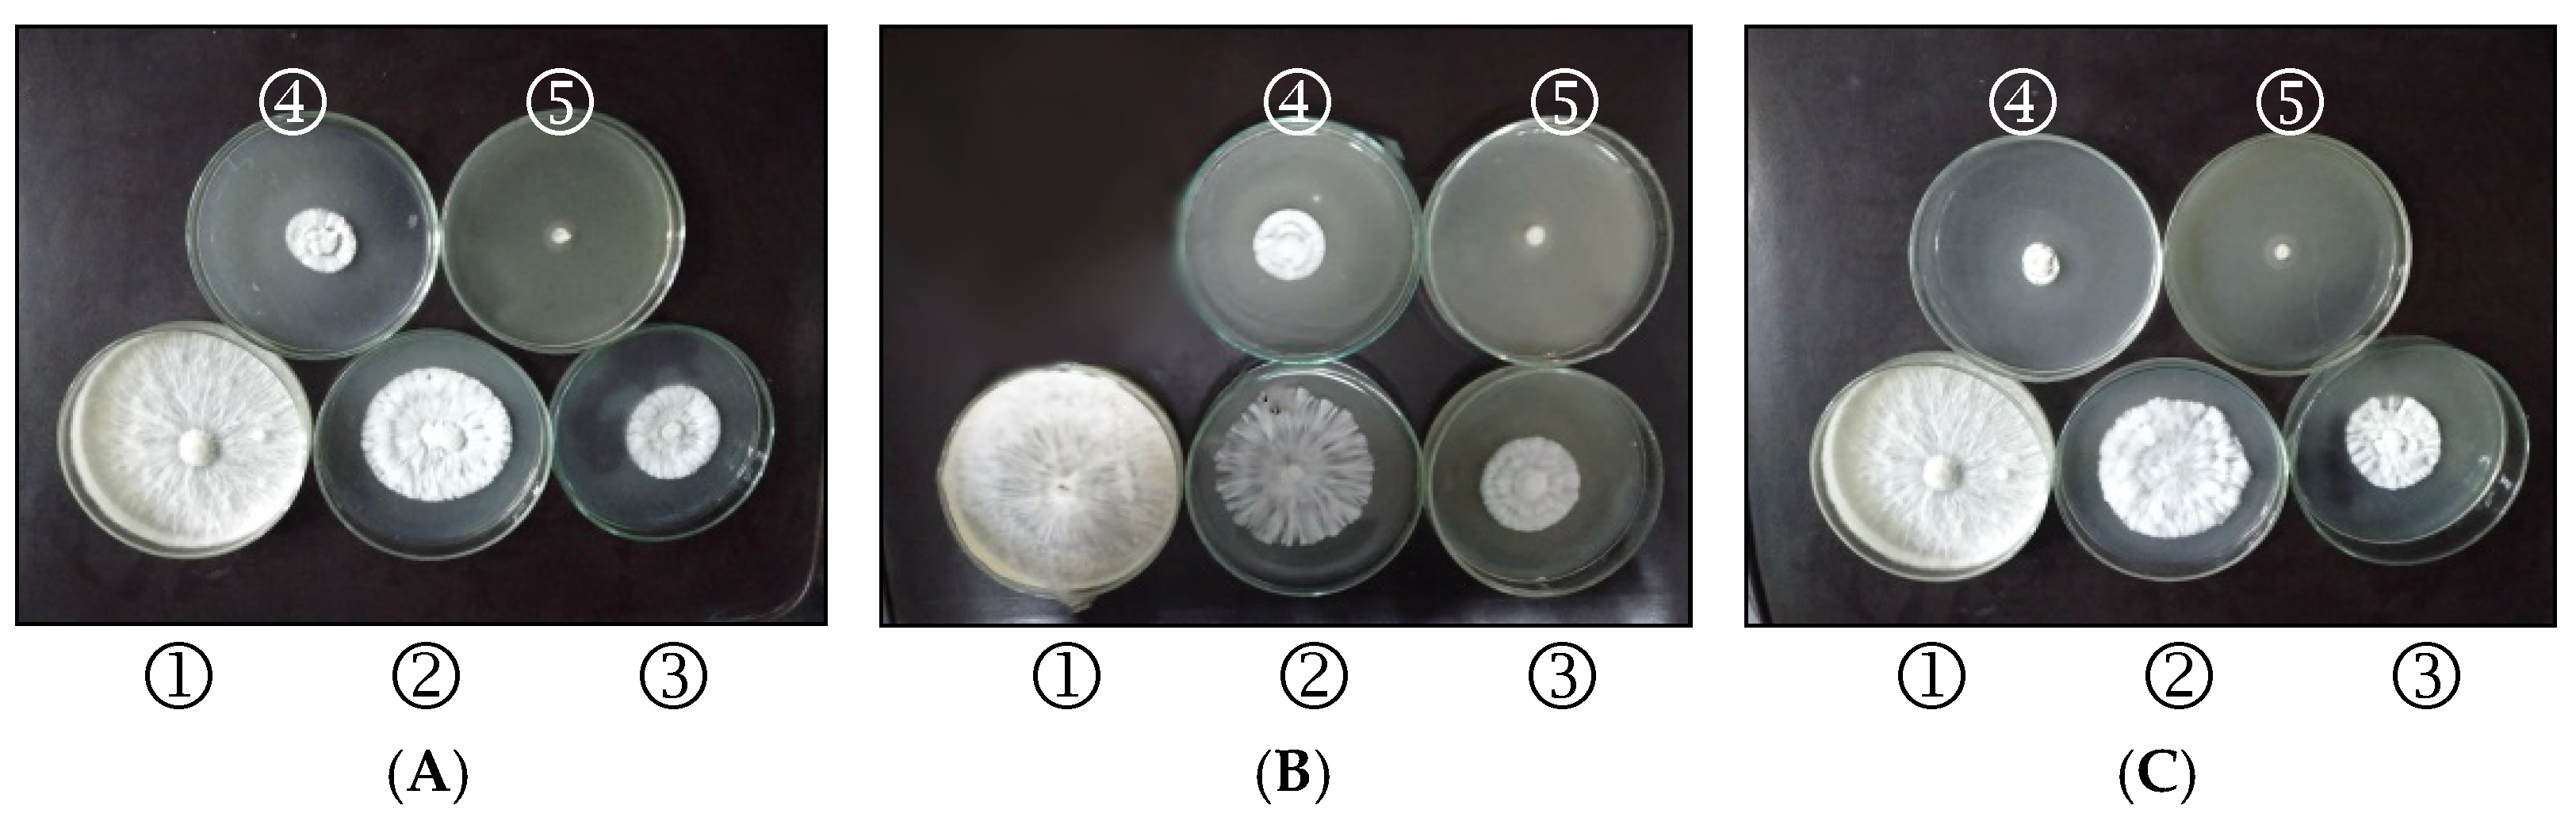
Plants 11 03542 g001 Plants 11 03542 g001

Evaluation of the Fungicidal Effect of Some Commercial Disinfectant and Sterilizer Agents Formulated as Soluble Liquid against Sclerotium rolfsii Infected Tomato Plant
Abstract
1. Introduction
2. Results
2.1. Characterization of Formulation Components
2.2. Physicochemical Properties of Spray Solution at the Recommended Field Dilution Rate (1.5%)
2.3. The Antifungal Activity of Disinfectant and Atrio (80%) on S. Rolfsii by Poisoned Food Technique In Vitro
2.4. The Antifungal Activity of Disinfectant and Atrio (80%) on S. rolfsii (Greenhouse Conditions)
2.4.1. Effect of disinfectant agents at different concentrations and Atrio 80% on the incidence of tomato root rots caused by S. rolfsii at 35 DAP (greenhouse conditions)
2.4.2. Effect of Disinfectant Agents at Different Concentrations and Atrio 80% on Growth Parameters of Tomato Seedlings Infected by S. rolfsii at 35 DAP
2.4.3. Effect of Disinfectant Agents at Different Concentrations and Atrio 80% on Metabolite of Tomato Seedlings Infected by S. rolfsii at 35 DAP
3. Discussion
4. Materials and Methods
4.1. Tested Materials
4.1.1. Commercial Disinfectants
- Chloroxylenol, or para-chloro-meta-xylenol (PCMX), is a mixture of 4.8% chloroxylenol + 9.9% terpineol and absolute alcohol. It was supplied by Agricultural Development Markets, Nadi El Seid St., Dokki, Giza.
- Phenic contains more than 98% high-quality, high-impact saponified tar oils and carbonates. It has between 6.5 and 7% pure phenol, a highly effective disinfectant. It is produced by the International Company for Chemicals and Industrial Detergents (Cairo, Egypt).
4.1.2. Active Ingredient
4.1.3. Surface-Active Agents
- Sisi-6, an anionic surfactant prepared by neutralizing aryl alkyl sulphonic acid with alkaline.
- Polyethylene glycol 600 di-laurate (PEG 600 DL) (Alexandria, Egypt), a nonionic surfactant supplied by The National Company for Starch, Yeast and Detergents, Alexandria.
- Polyethylene glycol 600 mono laurate (PEG 600 ML), a nonionic surfactant, supplied by The National Company for Starch, Yeast and Detergents, Alexandria.
4.2. Physico-Chemical Properties of Basic Formulation Constituents
4.2.1. Active Ingredient
- Solubility is determined by measuring the volume of distilled water, acetone and xylene for complete solubility or miscibility of one gram of an active ingredient at 20°C [32]. The solubility (%) was calculated according to the following equation:W = Active ingredient weight, V = Volume of solvent required for complete solubility.
4.2.2. Surface-Active Agents
- Surface tension was measured using a Du-Nouy tensiometer for solutions containing a 0.5% (w/v) surface-active agent following the American Society of Testing Materials [35].
- Hydrophilic–lipophilic balance (HLB): The solubility of a surfactant in water was used to approximate its hydrophilic–lipophilic balance [14].
- Critical micelle concentration (CMC): The concentration of the tested surfactants at which the surface tension of the solution does not decrease as the surfactant concentration increases (CMC) was determined using the technique given by the Ref. [13].
- Free-acidity or alkalinity was determined as mentioned previously.
4.3. Preparation of Phenol as Soluble Concentrate Formulation
4.4. Physicochemical Properties of Disinfectants before and after Storage
- Surface tension was determined as mentioned before.
- Free acidity or alkalinity was determined as mentioned previously.
- Accelerated storage was done to check the stability of local formulations at 54 ± 30 °C for three days according to the Ref. [35].
4.5. Determination of the Physico-Chemical Properties of the Spray Solution at the Field Dilution Rate
- Surface tension was measured using the du Nouy Tensiometer method described by the Ref. [36].
- The pH was determined using an Adwa (AD8000) pH meter [35].
- Viscosity was measured at room temperature with a “Brookfield DV II + PRO” digital viscometer and UL rotational adaptor (ULA) [37].
- Electrical Conductivity was measured using Cole–Parmer pH/Conductivity following the method described by the Ref. [35].
4.6. Isolation and Identification of the Fungal Pathogen
Antifungal Assay In Vitro
4.7. Greenhouse Experiment
- Total carbohydrates were determined and expressed as glucose according to the Shaffer–Somogi micro-method [44].
- Total protein content was determined indirectly using nitrogen concentration estimated by the semi-micro-Kjeldahl method, and a Kjeldahl conversion coefficient of 6.25 was used [45].
- Total phenols were determined using the colourimetric method of Folin–Denis as described by the Ref. [46].
- Proline content was determined according to the method described by the Ref. [47].
- Chlorophylls (a and b) and carotenoid concentrations were determined following the Ref. [48].
4.8. Statistical Analysis
5. Conclusions
Supplementary Materials
Author Contributions
Funding
Institutional Review Board Statement
Informed Consent Statement
Data Availability Statement
Acknowledgments
Conflicts of Interest
References
- Kimura, S.; Sinha, N. Tomato (Solanum lycopersicum): A model fruit-bearing crop. Cold Spring Harb. Protoc. 2008, 3, pdb.emo105. [Google Scholar] [CrossRef] [PubMed]
- Willcox, J.K.; Catignani, G.L.; Lazarus, S. Tomatoes and cardiovascular health. Crit. Rev. Food Sci. Nutr. 2003, 43, 1–18. [Google Scholar] [CrossRef]
- FAOSTATS. 2022. Available online: https://www.fao.org/faostat/en/#data/QCL (accessed on 15 August 2022).
- Flores-Moctezuma, H.E.; Montes-Belmont, R.; Jiménez-Pérez, A.; Nava-Juárez, R. Pathogenic diversity of Sclerotium rolfsii isolates from Mexico, and potential control of southern blight through solarization and organic amendments. Crop Prot. 2006, 25, 195–201. [Google Scholar] [CrossRef]
- De Curtis, F.; Lima, G.; Vitullo, D.; De Cicco, V. Biocontrol of Rhizoctonia solani and Sclerotium rolfsii on tomato by delivering antagonistic bacteria through a drip irrigation system. Crop Prot. 2010, 29, 663–670. [Google Scholar] [CrossRef]
- Ons, L.; Bylemans, D.; Thevissen, K.; Cammue, B.P. Combining biocontrol agents with chemical fungicides for integrated plant fungal disease control. Microorganisms 2020, 8, 1930. [Google Scholar] [CrossRef] [PubMed]
- Fan, F.; Hamada, M.S.; Li, N.; Li, G.Q.; Luo, C.X. Multiple fungicide resistance in Botrytis cinerea from greenhouse strawberries in Hubei Province, China. Plant Dis. 2017, 101, 601–606. [Google Scholar] [CrossRef]
- Mark, L.W. Overview of antiseptics and disinfectants. In Merck Sharp and Dohme Corp; A Subsidiary of Merck and Co. Inc.: Kenilworth, NJ, USA, 2015. [Google Scholar]
- El Mahmood, A.M.; Doughari, J.H. Effect of Dettol® on viability of some microorganisms associated with nosocomial infections. Afr. J. Biotechnol. 2008, 7, 1554–1562. [Google Scholar]
- Emam, M.A.; Abd EL-Mageed, A.M.; Niedbała, G.; Sabrey, S.A.; Fouad, A.S.; Kapiel, T.; Piekutowska, M.; Mahmoud, S.A. Genetic Characterization and Agronomic Evaluation of Drought Tolerance in Ten Egyptian Wheat (Triticum Aestivum L.) Cultivars. Agronomy 2022, 12, 1217. [Google Scholar] [CrossRef]
- Ismail, M.A.; Amin, M.A.; Eid, A.M.; Hassan, S.E.-D.; Mahgoub, H.A.M.; Lashin, I.; Abdelwahab, A.T.; Azab, E.; Gobouri, A.A.; Elkelish, A.; et al. Comparative Study between Exogenously Applied Plant Growth Hormones versus Metabolites of Microbial Endophytes as Plant Growth-Promoting for Phaseolus Vulgaris L. Cells 2021, 10, 1059. [Google Scholar] [CrossRef]
- El-Attal, Z.M.; Sawy, M.S.S.; Said, A.A.A. Laboratory studies on some Egyptian granular carrier for Linden and Endrin. Bull. End. Sci. Egypt Econ. Ser. 1974, 8, 7–11. [Google Scholar]
- Hashim, A.M.; Alharbi, B.M.; Abdulmajeed, A.M.; Elkelish, A.; Hozzein, W.N.; Hassan, H.M. Oxidative Stress Responses of Some Endemic Plants to High Altitudes by Intensifying Antioxidants and Secondary Metabolites Content. Plants 2020, 9, 869. [Google Scholar] [CrossRef] [PubMed]
- Lynch, M.I.; Griffin, W.C. Food Emulsions. In Emulsion Technology; Lissant, K.J., Ed.; Marcell Decker Inc.: New York. NY, USA, 1974; Mukerjee, P.; Mysels, K.J. Critical Micelle Concentration of Aqueous Surfactant Systems; National Bureau of Standards: Washington, DC, USA, 1971; pp. 1–21. [Google Scholar]
- Giovannucci, E. Tomatoes, tomato-based products, lycopene, and cancer: Review of the epidemiologic literature. J. Natl. Cancer Inst. 1999, 91, 317–331. [Google Scholar] [CrossRef] [PubMed]
- Billah, K.M.M.; Hossain, M.B.; Prince, M.H.; Sumon, M.D.M.P. Pathogenicity of Sclerotium rolfsii on different host, and its over wintering survival: A mini-review. Int. J. Adv. Agric. Sci. 2017, 2, 1–6. [Google Scholar]
- Yaqub, F.; Shahzad, S. Pathogenicity of Sclerotium rolfsii on different crops and effect of inoculum density on colonization of mungbean and sunflower roots. Pak. J. Bot. 2005, 37, 175–180. [Google Scholar]
- Erper, I.; Turkkan, M.; Karaca, G.H.; Kilic, G. Evaluation of in vitro antifungal activity of potassium bicarbonate on Rhizoctonia solani AG 4 HG-I, Sclerotinia sclerotiorum and Trichoderma sp. Afr. J. Biotechnol. 2011, 10, 8605–8612. [Google Scholar]
- Mellefont, L.A.; McMeekin, T.A.; Ross, T. The effect of abrupt osmotic shifts on the lag phase duration of foodborne bacteria. Int. J. Food Microbiol. 2003, 83, 281–293. [Google Scholar] [CrossRef]
- Fishel, F.M. Pesticide Formulations; EDIS: Singapore, 2010. [Google Scholar]
- FAO/WHO. Manual on Development and Use of FAO and WHO Specifications for Pesticides, 1st ed.; 3rd Rev. FAO Plant Production and Protection, FAO: Rome, Italy, 2010; Volume 36, p. 3. [Google Scholar]
- El-Sisi, A.G. Preparation of some insecticidal formulations using local constituent and testing their efficiency. Foliar pests of watermelon in Hawaii. Tropical Manag. 1985, 35, 90–96. [Google Scholar]
- Libs, E.S.; EL Salim, R.A. Formulation of essential oil pesticides technology and their application. Agric. Res. Tech. 2017, 9, 42–60. [Google Scholar]
- Hala, M.I.; Hanan, S.T.; Naglaa, K.Y. Effect of storage on the stability and biological effectiveness of some insecticides. J. Biol. Chem. Environ. Sci. 2016, 11, 265–282. [Google Scholar]
- Pereira, V.J.; da Cunha, J.R.; De Morais, T.P.; Ribeiro-Oliveira, J.P.; De Morais, J.B. Physical-chemical properties of pesticides: Concepts, applications, and interactions with the environment. J. Biosci. 2016, 32, 627–641. [Google Scholar] [CrossRef]
- Spanoghe, P.; De Schampheleire, M.; Van der Meeren, P.; Steurbaut, W. Influence of agricultural adjuvants on droplet spectra. Pest Manag. Sci. 2007, 63, 4–16. [Google Scholar] [CrossRef] [PubMed]
- El-Sisi, A.G.; El-Mageed, A.; El-Asawi, T.F.; El-Sharkawy, R.A. Improvement the physico-chemical properties and efficiency of some insecticides formulation by using adjuvants against cotton leafworm Spodoptera littoralis (BOISD.). J. Plant Prot. Pathol. 2011, 2, 757–764. [Google Scholar] [CrossRef]
- Nowrozi, H.; Kazemi, A.; MotallebiKhah, F.; Ghooshchi, F.; Sharabiani, A.K. Antifungal activity of benzalkonium chloride, Dettol, and chlorhexidine on opportunistic isolated fungi from the environment and operating rooms in private clinics of Tehran in 2011. J. Birjand Univ. Med. Sci. 2013, 20, 305–311. [Google Scholar]
- Abed, A.R.; Hussein, I.M. In vitro study of antibacterial and antifungal activity of some common antiseptics and disinfectants agents. Kufa J. Vet. Med. Sci. 2016, 7, 148–159. [Google Scholar]
- Ascenzi, J.M. Chloroxylenol: An old-new antimicrobial. In Handbook of Disinfectants and Antiseptics; M. Dekker: New York, NY, USA, 1996. [Google Scholar]
- Hura, K.; Hura, T.; Dziurka, K.; Dziurka, M. Carbohydrate, phenolic and antioxidant level in relation to chlorophyll A content in oilseed winter rape (Brassica napus L.) inoculated with Leptosphaeria maculans. Eur. J. Plant Pathol. 2015, 143, 291–303. [Google Scholar] [CrossRef]
- Nelson, F.C.; Fiero, G.W. Pesticide formulations, a selected aromatic fraction naturally occurring in petroleum as a pesticide solvent. J. Agric. Food Chem. 1954, 2, 735–737. [Google Scholar] [CrossRef]
- W.H.O. Specification of Pesticides Used in Public Health, 5th ed.; WHO: Geneva, Switzerland, 1979. [Google Scholar]
- Dobrat, W.; Martijn, A. Physic-Chemical Methods for Technical and Formulated Pesticides; Collaborative International Pesticides Analytical Council: Harpenden, UK, 1995. [Google Scholar]
- D133; American Society of Testing and Materials Standard Test Method For Surface and Inter Facial Tension of Solution of Surface-Active Agents. ASTM: West Conshohocken, PA, USA, 2001.
- D-1331-14; American Society of Testing and Materials Standard Test Methods for Surface and Interfacial Tension of Solution of Surface-Active Agents. ASTM: West Conshohocken, PA, USA, 2014.
- 2196–15; American Society of Testing and Materials Standard Test Methods for Rheological Properties of Non-Newtonian Materials by Rotational (Brookfield viscometer DV+II pro.) ASTM-D. ASTM: West Conshohocken, PA, USA, 2015.
- Burr, T.J.; Hunter, J.E.; Ogawa, J.M.; Abawi, G.S. A root rot of apple caused by Rhizoctonia solani in New York nurseries. Plant Dis. Rep. 1978, 62, 476–479. [Google Scholar]
- Dhingra, O.D.; Sinclair, J.B. Basic Plant Pathology Method; CRC, Boca: Raton, FL, USA, 1984. [Google Scholar]
- Barnett, H.L.; Hunter, B.B. Illustrated genera of imperfect fungi. Mac Millan Publishing Company; New York and Mac Millan Publishers: London, UK, 1987; 220p. [Google Scholar]
- Mohanty, R.C.; Ray, P.; Rath, S. In-vitro antifungal efficacy study of plant leaf extracts against three dermatophytes. CIB Tech. J. Microbiol. 2012, 1, 27–32. [Google Scholar]
- Satya, P.R.; Manisha, S.P.; Khushboo, S. Evaluation of the antifungal activity of the potent fraction of hexane extract obtained from the bark of Acacia nilotica. Int. J. Sci. Res. 2014, 3, 730–738. [Google Scholar]
- El-Mohamedy, R.S.R.; Jabnoun-Khiareddine, H.; Daami-Remadi, M. Control of root rot diseases of tomato plants caused by Fusarium solani, Rhizoctonia solani and Sclerotium rolfsii using different chemical resistance inducers. Tunis. J. Plant Prot. 2014, 9, 45–55. [Google Scholar]
- Association of Official Agriculture Chemists (A.O.A.C.). Official Methods of Analysis, 12th ed.; A.O.A.C.: Washington, DC, USA, 1995. [Google Scholar]
- Juliano, B.O. Rice in Human Nutrition; (FAO Food and Nutrition Series. No. 26); FAO: Rome, Italy, 1993; ISBN 92-5-103149-5. [Google Scholar]
- Baba, S.A.; Malik, S.A. Determination of total phenolic and flavonoid content, antimicrobial and antioxidant activity of a root extract of Arisaema jacquemontii Blume. J. Taibah Univ. Sci. 2015, 9, 449–454. [Google Scholar] [CrossRef]
- Bates, L.S.; Waldren, R.P.; Teare, I.D. Rapid determination of free proline for water-stress studies. Plant Soil 1973, 39, 205–207. [Google Scholar] [CrossRef]
- Arnon, D.I. Copper enzymes in isolated chloroplast. Polyphenol-oxidase in Beta Vulgaris L. Plant Physiol. 1949, 24, 1–5. [Google Scholar] [CrossRef] [PubMed]
- Gomez, K.A.; Gomez, A.A. Statistical Procedures for Agriculture Research, 2nd ed.; June Wiley & Sons. Inc.: New York, NY, USA, 1984. [Google Scholar]

| Solubility % (w/v) | Free Acidity as % H2SO4 | ||
|---|---|---|---|
| Water | Acetone | Xylene | |
| 33 | 100 | 62.5 | 0.098 |
| Surface Active Agent | Surface Tension (dyne/cm) at CMC | CMC% | HLB | Free Acidity as % H2SO4 |
|---|---|---|---|---|
| Sisi 6 | 28.5 | 0.5 | >13 | 0.245 |
| PEG 600 ML | 30.64 | 0.3 | >13 | 0.882 |
| PEG 600 DL | 30.23 | 0.4 | 10–12 | 0.049 |
| Storage | Physicochemical Properties | Commercial Disinfectants | ||
|---|---|---|---|---|
| Phenol Formulated | Chloroxylenol | Phenic | ||
| Before storage | Surface tension (dyne/cm) | 40 | 36.97 | 36.97 |
| Free acidity as % H2SO4 | 0.249 | 0 | 0 | |
| Free alkalinity as % NaOH | 0.0 | 0.72 | 1.84 | |
| Solubility | Soluble | Soluble | Soluble | |
| Sedimentation | nil | nil | nil | |
| After storage | Surface tension (dyne/cm) | 38 | 36.97 | 36 |
| Free acidity as % H2SO4 | 0.249 | 0 | 0 | |
| Free alkalinity as % NaOH | 0 | 0.52 | 1.84 | |
| Solubility | Soluble | Soluble | Soluble | |
| Sedimentation | nil | nil | nil | |
| Compounds | Physico-Chemical Properties | |||
|---|---|---|---|---|
| Surface Tension (dyne /cm) | pH Value | Conductivity (µMHOS) | Viscosity (cm/poise) | |
| Water | 72 | 9.21 | 350 | 0.89 |
| Phenol | 34.79 | 7.51 | 370 | 1.19 |
| Formulated phenol (7%) | 28 | 7.42 | 425 | 1.71 |
| Chloroxylenol (10%) | 34.58 | 8.46 | 448 | 1.20 |
| Phenic (10%) | 33.44 | 8.94 | 585 | 1.70 |
| Compounds | Concentrations (µL/L) | EC50 | EC90 | Slope Value | |||
|---|---|---|---|---|---|---|---|
| 1000 | 2000 | 3000 | 4000 | ||||
| Formulated phenol (7%) | 33.33 | 55.55 | 72.22 | 100 | 3.1239 +/– 0.3266 | 3995.7593 | 1553.59 |
| Chloroxylenol (10%) | 36.66 | 64.44 | 88.88 | 100 | 3.2679 +/– 0.3469 | 3324.9652 | 1347.74 |
| Phenic (10%) | 38.88 | 58.88 | 85.55 | 100 | 3.123 +/– 0.3341 | 3525.7869 | 1370.52 |
| Treatments | Concentrations | Disease Incidence (%) | Disease Reduction (%) |
|---|---|---|---|
| Control infected soil | N/A * | 93.75 | 0.00 |
| Control sterilized soil | N/A | 0.00 | 100.00 |
| Formulated phenol (7%) | 125µL 100 mL−1 | 43.75 | 53.33 |
| 250µL 100 mL−1 | 25.00 | 73.33 | |
| 500µL 100 mL−1 | 18.75 | 80.00 | |
| 1000µL 100 mL−1 | 12.50 | 86.67 | |
| Chloroxylenol (10%) | 125µL 100 mL−1 | 37.50 | 60.00 |
| 250µL 100 mL−1 | 31.25 | 66.67 | |
| 500µL 100 mL−1 | 56.25 | 40.00 | |
| Phenic (10%) | 125µL 100 mL−1 | 43.75 | 53.33 |
| 250µL 100 mL−1 | 56.25 | 40.00 | |
| 500µL 100 mL−1 | 66.60 | 28.96 | |
| Atrio (80%) | 2 g L−1 | 12.50 | 86.67 |
Publisher’s Note: MDPI stays neutral with regard to jurisdictional claims in published maps and institutional affiliations. |
© 2022 by the authors. Licensee MDPI, Basel, Switzerland. This article is an open access article distributed under the terms and conditions of the Creative Commons Attribution (CC BY) license (https://creativecommons.org/licenses/by/4.0/).
Share and Cite
Hussien, R.A.A.; Gnedy, M.M.A.; Sayed, A.A.S.; Bondok, A.; Alkhalifah, D.H.M.; Elkelish, A.; Tawfik, M.M. Evaluation of the Fungicidal Effect of Some Commercial Disinfectant and Sterilizer Agents Formulated as Soluble Liquid against Sclerotium rolfsii Infected Tomato Plant. Plants 2022, 11, 3542. https://doi.org/10.3390/plants11243542
Hussien RAA, Gnedy MMA, Sayed AAS, Bondok A, Alkhalifah DHM, Elkelish A, Tawfik MM. Evaluation of the Fungicidal Effect of Some Commercial Disinfectant and Sterilizer Agents Formulated as Soluble Liquid against Sclerotium rolfsii Infected Tomato Plant. Plants. 2022; 11(24):3542. https://doi.org/10.3390/plants11243542
Chicago/Turabian StyleHussien, Rania A. A., Mai M. A. Gnedy, Ali A. S. Sayed, Ahmed Bondok, Dalal Hussien M. Alkhalifah, Amr Elkelish, and Moataz M. Tawfik. 2022. "Evaluation of the Fungicidal Effect of Some Commercial Disinfectant and Sterilizer Agents Formulated as Soluble Liquid against Sclerotium rolfsii Infected Tomato Plant" Plants 11, no. 24: 3542. https://doi.org/10.3390/plants11243542
APA StyleHussien, R. A. A., Gnedy, M. M. A., Sayed, A. A. S., Bondok, A., Alkhalifah, D. H. M., Elkelish, A., & Tawfik, M. M. (2022). Evaluation of the Fungicidal Effect of Some Commercial Disinfectant and Sterilizer Agents Formulated as Soluble Liquid against Sclerotium rolfsii Infected Tomato Plant. Plants, 11(24), 3542. https://doi.org/10.3390/plants11243542

